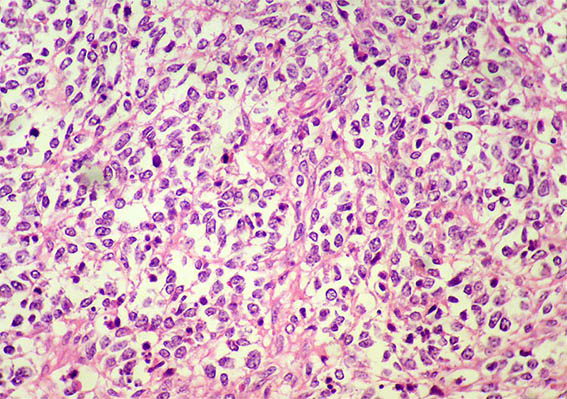
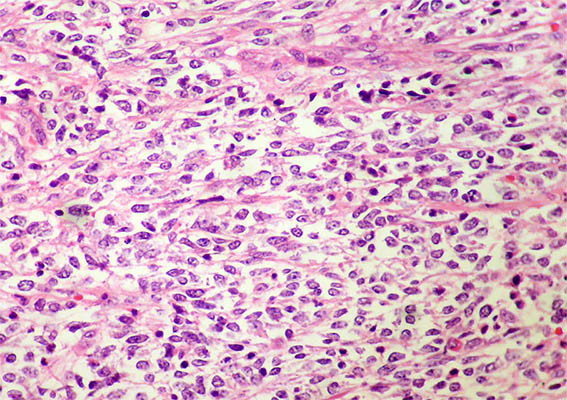
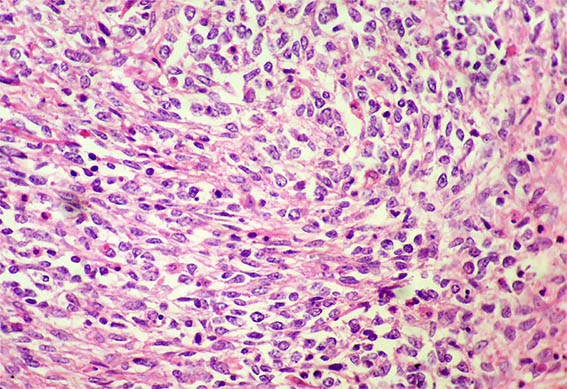
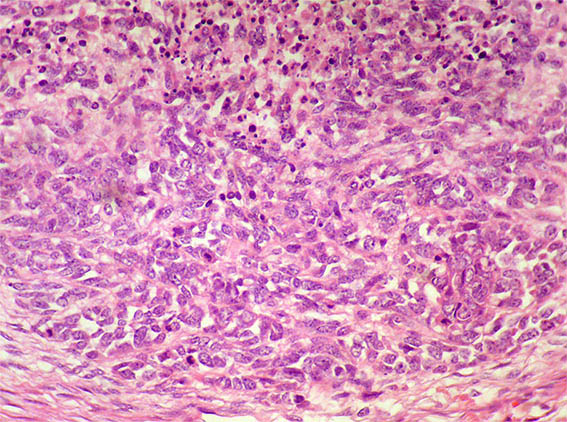

|
|
CASE
216 (February 2024)
Clinical information
A 4-year-old boy presents with a right renal mass that replaces the kidney by 70%. With a diagnostic impression of Wilms tumor, preoperative chemotherapy was initiated. After 8 weeks of treatment there does not seem to be an adequate response and a nephrectomy is performed. There is no personal pathological history. There are no extrarenal lesions.
Look at the images.

Figure 1.

Figure 2. Closer image.

Figure 3.
H&E, X100.

Figure 4. H&E, X200.
Figure 5. H&E, X400.

Figure 6. H&E, X400.
Figure 7. H&E, X400.

Figure 8. H&E, X400.
Figure 9. H&E, X400.
Figure 10. H&E, X400.

Figure 11. Immunohistochemistry for WT1 completely negative, X400.

Figure 12. Immunohistochemistry for Cyclin D1: diffuse nuclear positivity, X400.
Myogenin, CD99, CD45, S100, chromogranin, synaptophysin, cytokeratins: Negative. INI1: diffuse nuclear positivity.
What is your diagnosis?
See
diagnosis and discussion
[Top]
|
|